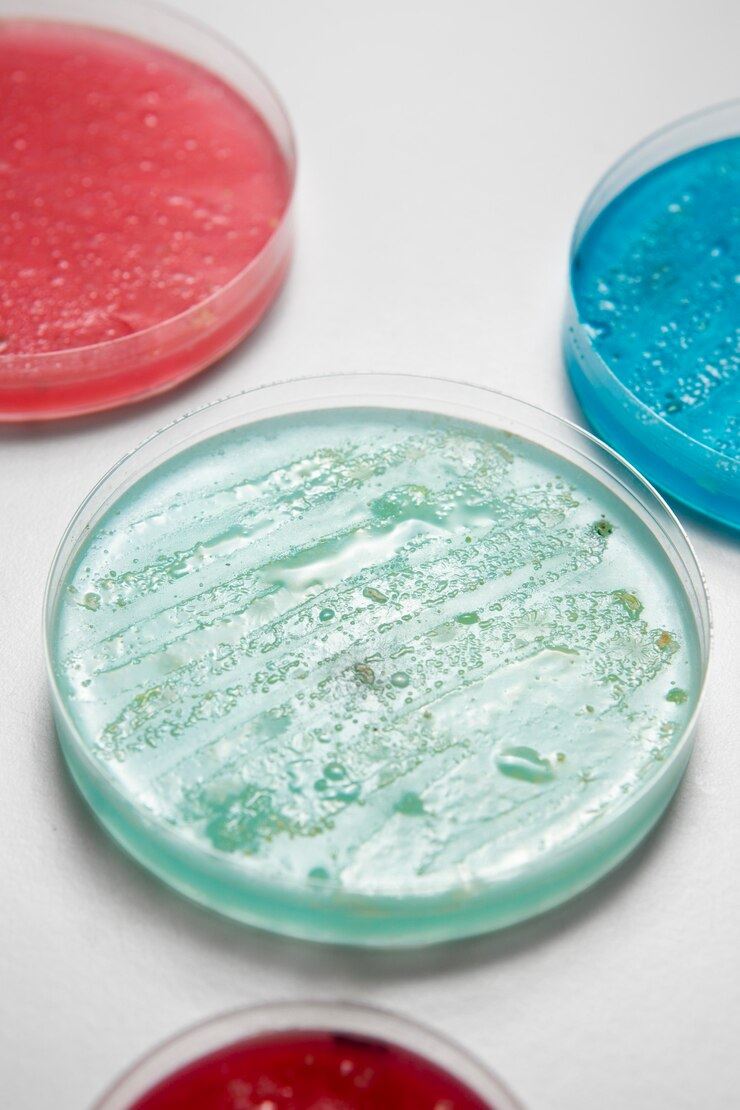
Microbiology plates

MIB-CM® Microbiology Reagents
Distributed under Freepik License, from Freepik.
Distributed under Freepik License, from Freepik.
Creative Biolabs is a world leading biotechnological company in research and development of agents in the field of antifungal and antibacterial drug discovery. Based on years of experience and advanced platforms, we promise to offer best-in-class products to meet the need of our customers.
Microbiology is the study of microscopic organisms, which include bacteria, viruses, archaea, fungi, etc. Medical microbiology focuses on the prevention, diagnosis, and treatment of infectious diseases. The human body is heavily fortified against attack by disease-causing agents but also succumb to a series of infectious pathogens, such as bacterial infections, fungal infections, parasitic infections, and viral infections.
A few harmful microbes cause infectious diseases such as measles flu and also non-infectious chronic diseases. In response to the increasing risk of drug-resistant bacteria, we have developed the one-stop antifungal drug discovery platform and one-stop antibacterial drug discovery platform. What's more, Creative Biolabs provides a series of MIB-CM® reagents to assist microbiology research for our customs all over the world.
Features of our Products
- Low price and good quality
- Fast product transportation and short cycle
- Variety to meet different needs
- Support a large number of orders
 Distributed under Freepik License, from Freepik.
Distributed under Freepik License, from Freepik.
 Distributed under Freepik License, from Freepik.
Distributed under Freepik License, from Freepik.
For Research Use Only.
